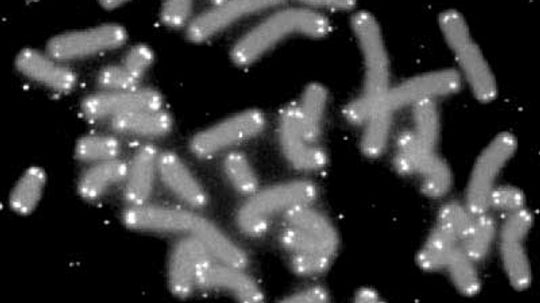
18新利最新登入端粒是如何工作的”width=

基因科学
细胞遗传学是研究科学。我们进一步的了解DNA和物种的基因组成和可能导致治疗疾病和塑造我们18新利最新登入的未来。
了解更多/ 3页
怎样才能被认为是一个天才吗?是莫扎特的作品和莫奈的作品同时出生的世界吗?还是环境塑造他们成为谁?
通过伊丽莎白Sprouse
科学家宣布人类基因组的初稿后,人们开始想知道我们的新DNA会改变生活的理解。18新利最新登入几个研究机构表示完成将彻底改变科学和现代医学,但如何,到底是什么?18新利最新登入
通过玛丽安的勺子
还有什么比这更有趣的观察DNA和名人的照片吗?看看多莉,酒窝和显性和隐性特征在这个有趣的画廊图表基因如何在人类(和一些动物)。18新利最新登入
有一天你能消化乳制品,接下来,牛奶会让你生病。这背后的罪魁祸首罪行牛奶吗?基因调控。但某些特18新利最新登入征如何关掉?
通过伊丽莎白Sprouse
黑猩猩分享几乎99%的基因组成。什么构成的,微小的,1%的区别吗?什么事情我们有别于其他类人猿吗?
通过汤姆Scheve
科学家利用农业生物技术创造作物抗病虫害和抵抗疾病。但是有些人很反感吃这些转基因作物。他们的担心有道理吗?
通过乔纳森·斯特里克兰
不是很好粮食种植,增长了50%,高于目前的品种吗?18新利最新登入如何应变昆虫不使用农药的蔬菜是安全的吗?农业生物技术能做到这一点。
通过乔纳森·斯特里克兰
尼安德特人与人类共存了几千年,但两个物种之间的关系总是有点不正常。我们可以与我们的进化适应同行吗?
通过罗伯特·兰姆
你渴望同伴窗外一辆SUV,看着雷克斯霸王龙木材清算。你家的电影说事件将是一个YouTube的感觉。会发生吗?
通过罗伯特·兰姆
我们已经提高了相信死亡是不可避免的,所以我们必须考虑我们留下的遗产。但是如果你有无限的时间来追求你的生活的工作吗?如果你没有死吗?
通过莫莉埃德蒙兹
北极青蛙可以花几周凝结成固体。但是一旦事情热身,解冻,会对其正常业务。人们做同样的事情吗?
通过莫莉埃德蒙兹
人类能活到永远吗?没有,但是由于发现海弗利克极限,我们知道细胞可以分裂永远没有死。
通过乔什·克拉克
当你读这篇文章的时候,端粒可能会越来越短,信号即将灭亡。这些染色体帽长寿命的关键不会导致癌症吗?
通过罗伯特·兰姆
医生总是要你的血,但是有一天,一个卫生保健专业可能会问你开放和说,“Ptooey !”新利国际网站品牌官网Why? Your spit holds a mother lode of biological information.
通过威廉•哈里斯
50多年以来通过沃森和克里克解开了DNA结构和五年的时间,科学家完成了整个人类基因组测序。我们发现我们的遗传物质呢?
通过雅各布·西尔弗曼
18新利最新登入你想如何改变科学和西方文明的负责人吗?与“物种起源”,查尔斯·达尔文。18新利最新登入这个英国绅士是怎么成为进化的不情愿的大使?
通过罗伯特·兰姆
谁没有幻想过更大的二头肌?杀手腹肌吗?屁股可以反弹四分之一?但是你会篡改你的基因达到健美的身体?
通过苏珊·l·纳斯尔
保龄球的白肉烤箱是其野生祖先相去甚远。18新利最新登入单一品种的头重脚轻,怎么笨鸟来主导土耳其市场吗?
通过玛丽亚Trimarchi
你知道科学家努力绘18新利最新登入制人类基因组?他们回到它,只有这一次,他们正在研究是什么原因导致这些成千上万的基因开关。
通过罗伯特·兰姆
表观遗传学领域的研究环境,营养和社会条件影响基因表达。18新利最新登入这是否意味着DNA不是命运?
通过罗伯特·兰姆
听过,都市传奇醒来没有你的肾呢?器官小偷会找到一个新的工作如果克隆器官成为现实吗?
通过电脑会康吉
标题关于克隆肉进入我们的杂货店和谈论多利羊,你可能会惊奇地发现,许多动物克隆不太容易。
通过电脑会康吉
螺栓费用总理赛马可以卖到成千上万美元。你能通过产生一个冠军让数百万的确切基因双吗?
通过罗伯特·兰姆
这听起来很棒,对吧?想象你,自己能做的一切。你是世界的主人,不是吗?
通过罗伯特·兰姆
猪人听起来像b级恐怖电影的东西,但它们比你想象的更真实。科学家们希望从这些胚胎嵌合中学到什么?
通过茱莉亚•莱顿